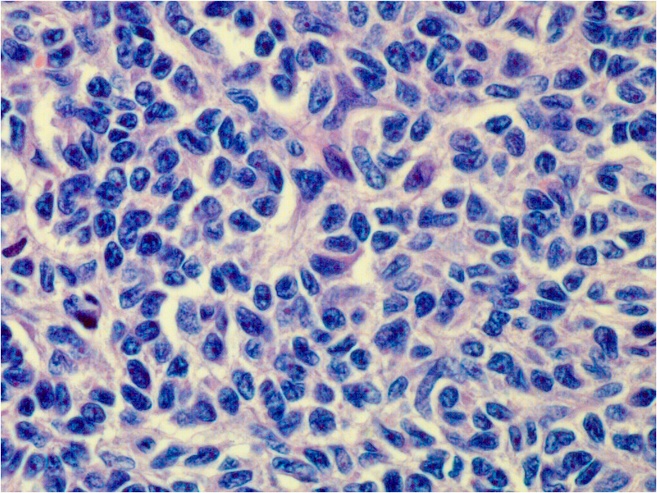

과립막 세포 종양
"오늘의AI위키"의 AI를 통해 더욱 풍부하고 폭넓은 지식 경험을 누리세요.
1. 개요
과립막 세포 종양은 난소에서 발생하는 희귀한 종양으로, 주로 성인형과 소아형으로 분류된다. 성인형은 폐경 후 여성에게서, 소아형은 15세 미만 소아에게서 주로 발생하며, 각각 FOXL2 유전자 돌연변이와 AKT1 효소와 관련이 있다. 에스트로겐을 생성하는 '기능성' 종양의 임상 양상은 환자의 연령과 성별에 따라 다르며, 여성의 경우 비정상 자궁 출혈, 월경과다, 조기 사춘기 등의 증상이 나타날 수 있다. 진단은 육안 소견, 조직학적 소견, 종양 표지자 검사를 통해 이루어지며, 인히빈이 종양 표지자로 사용된다. 늙어가는 다람쥐원숭이의 난소에서도 유사한 과립막 세포 덩어리가 발생한다.
더 읽어볼만한 페이지
- 소아암 - 골육종
골육종은 뼈, 특히 장골의 골간단 부위에서 발생하는 악성 종양으로, 밤에 심해지는 통증, 부종, 병적 골절 등의 증상을 보이며, 유전적, 환경적 요인이 복합적으로 작용하는 것으로 추정되고, 수술 및 항암화학요법을 통해 치료하며, 예후는 병기 및 치료 반응에 따라 달라진다. - 소아암 - 망막모세포종
망막모세포종은 소아에게 주로 나타나는 악성 종양으로, RB1 또는 MYCN 유전자 돌연변이가 원인이며, 백색동공, 시력 저하, 사시 등의 증상을 보이고, 안구 적출술, 방사선 치료, 화학 요법 등으로 치료하며, 종양 위험도 분류 체계를 통해 관리된다. - 남성과학 - 불임
불임은 피임 없이 1년 이상 정상적인 성생활을 했음에도 임신이 되지 않는 생식계 질환으로, 남성, 여성, 복합 요인 등 다양한 원인이 있으며, 심리적 문제와 사회적 압박감을 유발하고, 배란 유도, 인공 수정, 시험관 아기 시술 등 다양한 치료 방법이 활용된다. - 남성과학 - 정자 (생물학)
정자는 동물의 수컷 생식 세포로, 난자와 결합하여 수정을 통해 새로운 개체를 형성하며, 머리, 중간 부위, 꼬리로 구성되어 있으며, 인공 수정 등 의학적 시술에 활용되기도 한다. - 산부인과 암 - 자궁경부암
자궁경부암은 인유두종바이러스 감염이 주원인인 자궁 경부의 악성 종양으로, 초기에는 증상이 미미하지만 진행 시 질 분비물 증가, 성교통, 골반통이 나타날 수 있으며, 자궁경부 세포진 검사, 조직 생검 등으로 진단하고 수술, 방사선 치료, 항암 치료 등으로 치료하며, HPV 백신 접종과 정기 검진으로 예방이 가능하다. - 산부인과 암 - 난소암
난소암은 난소에서 발생하는 악성 종양으로 조기 발견이 어렵고 복부 팽만감, 빈뇨 등의 초기 증상이 나타나며, 발병 위험은 배란 횟수, 나이, 가족력 등과 관련 있고, 다산, 경구 피임약 복용 등은 위험을 낮추는 요인으로 작용하며, 영상 검사, 종양 표지자 검사, 조직검사 등을 통해 진단하고, 수술, 화학요법, 방사선 요법 등으로 치료하며, 최근에는 면역요법과 표적치료제 개발 연구가 활발히 진행되고, 예후는 병기와 암의 유형에 따라 달라진다.
2. 분류
과립막 세포종은 크게 성인형과 소아형으로 분류된다. 성인형은 FOXL2 유전자의 돌연변이와 관련이 있으며, 소아형은 AKT1 효소의 돌연변이와 관련이 있는 것으로 알려져 있다.
2. 1. 성인형 과립막 세포종

2. 2. 소아형 과립막 세포종
최근 두 연구에 따르면 효소 AKT1이 소아 과립막 세포 종양과 관련되어 있는 것으로 나타났다. 15세 미만의 소녀에게서 발생하는 소아 과립막 세포 종양의 60% 이상에서 단백질의 플렉스트린-상동성 도메인에 프레임 내 중복이 발견되었다. 중복이 없는 종양은 고도로 보존된 잔기를 침범하는 점 돌연변이를 가지고 있었다. 중복을 가진 돌연변이 단백질은 세포 내 분포가 야생형이 아니었으며, 세포막에서 현저한 농축을 보여 AKT1의 강한 활성화를 유도했다.[8] RNA 시퀀싱 분석을 통해 사이토카인 및 호르몬 신호 전달과 세포 분열 관련 과정에 관련된 일련의 차등 발현 유전자를 정확히 찾아냈다. 추가 분석 결과 탈분화 과정이 가능하며, 대부분의 전사체 이상 조절이 AKT1 활성화에 의해 교란된 제한된 전사 인자에 의해 매개될 수 있음을 시사했다. 이러한 결과는 AKT1의 체세포 돌연변이가 소아 과립막 세포 종양의 발병 과정에서 가능한 드라이버 사건임을 보여준다.[9]3. 임상 양상
에스트로젠은 '기능성' 종양에 의해 생성되며, 환자의 성별과 연령에 따라 임상 증상이 다르게 나타난다.[1]
3. 1. 여성
에스트로젠은 '기능성' 종양에 의해 생성되며, 임상적 증상은 환자의 연령에 따라 다르게 나타난다.[1]4. 유전학
과립막 세포종의 발생은 유전적 요인과 관련이 있다.
4. 1. 성인형 과립막 세포종
차세대 DNA 염기 서열 분석 결과, 성인 과립막 세포 종양의 97%에서 FOXL2 유전자 내에 동일한 체세포 돌연변이(c.402C>G, p. C134W)가 발견되었다. 이 돌연변이는 일반적으로 자손에게 전달되지 않으며, 과립막 세포 종양의 원인일 수 있다고 여겨진다.
4. 2. 소아형 과립막 세포종
최근 두 연구에 따르면 효소 AKT1이 소아 과립막 세포 종양에 관련되어 있는 것으로 나타났다. 15세 미만의 소녀에게서 발생하는 소아 과립막 세포 종양의 60% 이상에서 단백질의 플렉스트린-상동성 도메인에 프레임 내 중복이 발견되었다. 중복이 없는 종양은 고도로 보존된 잔기를 침범하는 점 돌연변이를 가지고 있었다. 중복을 가진 돌연변이 단백질은 세포 내 분포가 야생형이 아니었으며, 세포막에서 현저한 농축을 보여 AKT1의 강한 활성화를 유도했다.[8] RNA 시퀀싱 분석을 통해 사이토카인 및 호르몬 신호 전달과 세포 분열 관련 과정에 관련된 일련의 차등 발현 유전자를 정확히 찾아냈다. 추가 분석 결과 탈분화 과정이 가능하며, 대부분의 전사체 이상 조절이 AKT1 활성화에 의해 교란된 제한된 전사 인자에 의해 매개될 수 있음을 시사했다. 이러한 결과는 AKT1의 체세포 돌연변이가 소아 과립막 세포 종양의 발병 과정에서 가능한 드라이버 사건임을 보여준다.[9]5. 진단
과립막 세포 종양은 육안 소견, 종양 표지자, 조직병리학적 소견을 통해 진단할 수 있다. 육안으로는 종양의 크기가 작은 점에서 큰 덩어리에 이르기까지 다양하며, 평균 지름은 10cm이다. 종양은 타원형이며 부드러운 질감을 보인다.[1] 인히빈은 과립막 세포 종양의 종양 표지자로 사용되어 왔다.[10]
소아 과립막 세포 종양은 조직학적으로 성인 과립막 세포 종양과 구별될 수 있는데, 풍부한 호산성 세포질, 다각형 세포의 원시적이고 분열이 활발한 핵, 그리고 무질서한 소포를 가진다는 특징이 있다.[12][13]
5. 1. 육안 소견
종양의 크기는 작은 점에서 큰 덩어리에 이르기까지 다양하며, 평균 지름은 10cm이다. 종양은 타원형이며 부드러운 질감을 보인다.[1]5. 2. 종양 표지자
인히빈은 과립막 세포 종양의 종양 표지자로 사용되어 왔다.[10]5. 3. 조직병리학
소아 과립막 세포 종양은 조직학적으로 성인 과립막 세포 종양과 구별될 수 있는데, 풍부한 호산성 세포질, 다각형 세포의 원시적이고 분열이 활발한 핵, 그리고 무질서한 소포를 가진다는 특징이 있다.[12][13]
6. 동물에서의 발생
늙어가는 다람쥐원숭이의 난소에서는 사람의 과립막 세포 종양과 유사한 과립막 세포 덩어리가 발생한다.[14] 이는 이 종에서 나이가 들어감에 따라 나타나는 정상적인 변화로 보인다.
참조
[1]
웹사이트
Prognostic factors in adult granulosa
https://www.research[...]
[2]
논문
Juvenile granulosa cell tumor of the ovary. A clinic pathological analysis of 125 cases. Beth Israel Deaconess Medical Center, Boston
[3]
웹사이트
Program in Gynecologic Medical Oncology, Beth Israel Deaconess Medical Center, Boston
http://cat.inist.fr/[...]
[4]
서적
Gynaecology
Churchill Livingstone
[5]
논문
Juvenile granulosa cell tumor of testis: case report and review of literature
2008-04
[6]
논문
Juvenile granulosa cell tumor of adult testis: a case report
2008-07
[7]
논문
Spectrum of ovarian tumors in a referral hospital in Nepal
[8]
논문
A Hot-spot of In-frame Duplications Activates the Oncoprotein AKT1 in Juvenile Granulosa Cell Tumors
2015-03
[9]
논문
Molecular analyses of juvenile granulosa cell tumors bearing AKT1 mutations provide insights into tumor biology and therapeutic leads
2015-12
[10]
논문
Inhibin as a Marker for Granulosa-Cell Tumors
https://www.nejm.org[...]
1989-09-21
[11]
논문
Adult type granulosa cell tumor of the testis with a heterologous sarcomatous component: case report and review of the literature.
[12]
논문
Case 26-2023: A 15-Year-Old Girl with Abdominal Pain and an Ovarian Mass
http://www.nejm.org/[...]
2023-08-24
[13]
논문
Juvenile granulosa cell tumor of the ovary. A clinicopathological analysis of 125 cases
1984-08
[14]
논문
Ovarian aging in squirrel monkeys (Saimiri sciureus)
본 사이트는 AI가 위키백과와 뉴스 기사,정부 간행물,학술 논문등을 바탕으로 정보를 가공하여 제공하는 백과사전형 서비스입니다.
모든 문서는 AI에 의해 자동 생성되며, CC BY-SA 4.0 라이선스에 따라 이용할 수 있습니다.
하지만, 위키백과나 뉴스 기사 자체에 오류, 부정확한 정보, 또는 가짜 뉴스가 포함될 수 있으며, AI는 이러한 내용을 완벽하게 걸러내지 못할 수 있습니다.
따라서 제공되는 정보에 일부 오류나 편향이 있을 수 있으므로, 중요한 정보는 반드시 다른 출처를 통해 교차 검증하시기 바랍니다.
문의하기 : help@durumis.com
